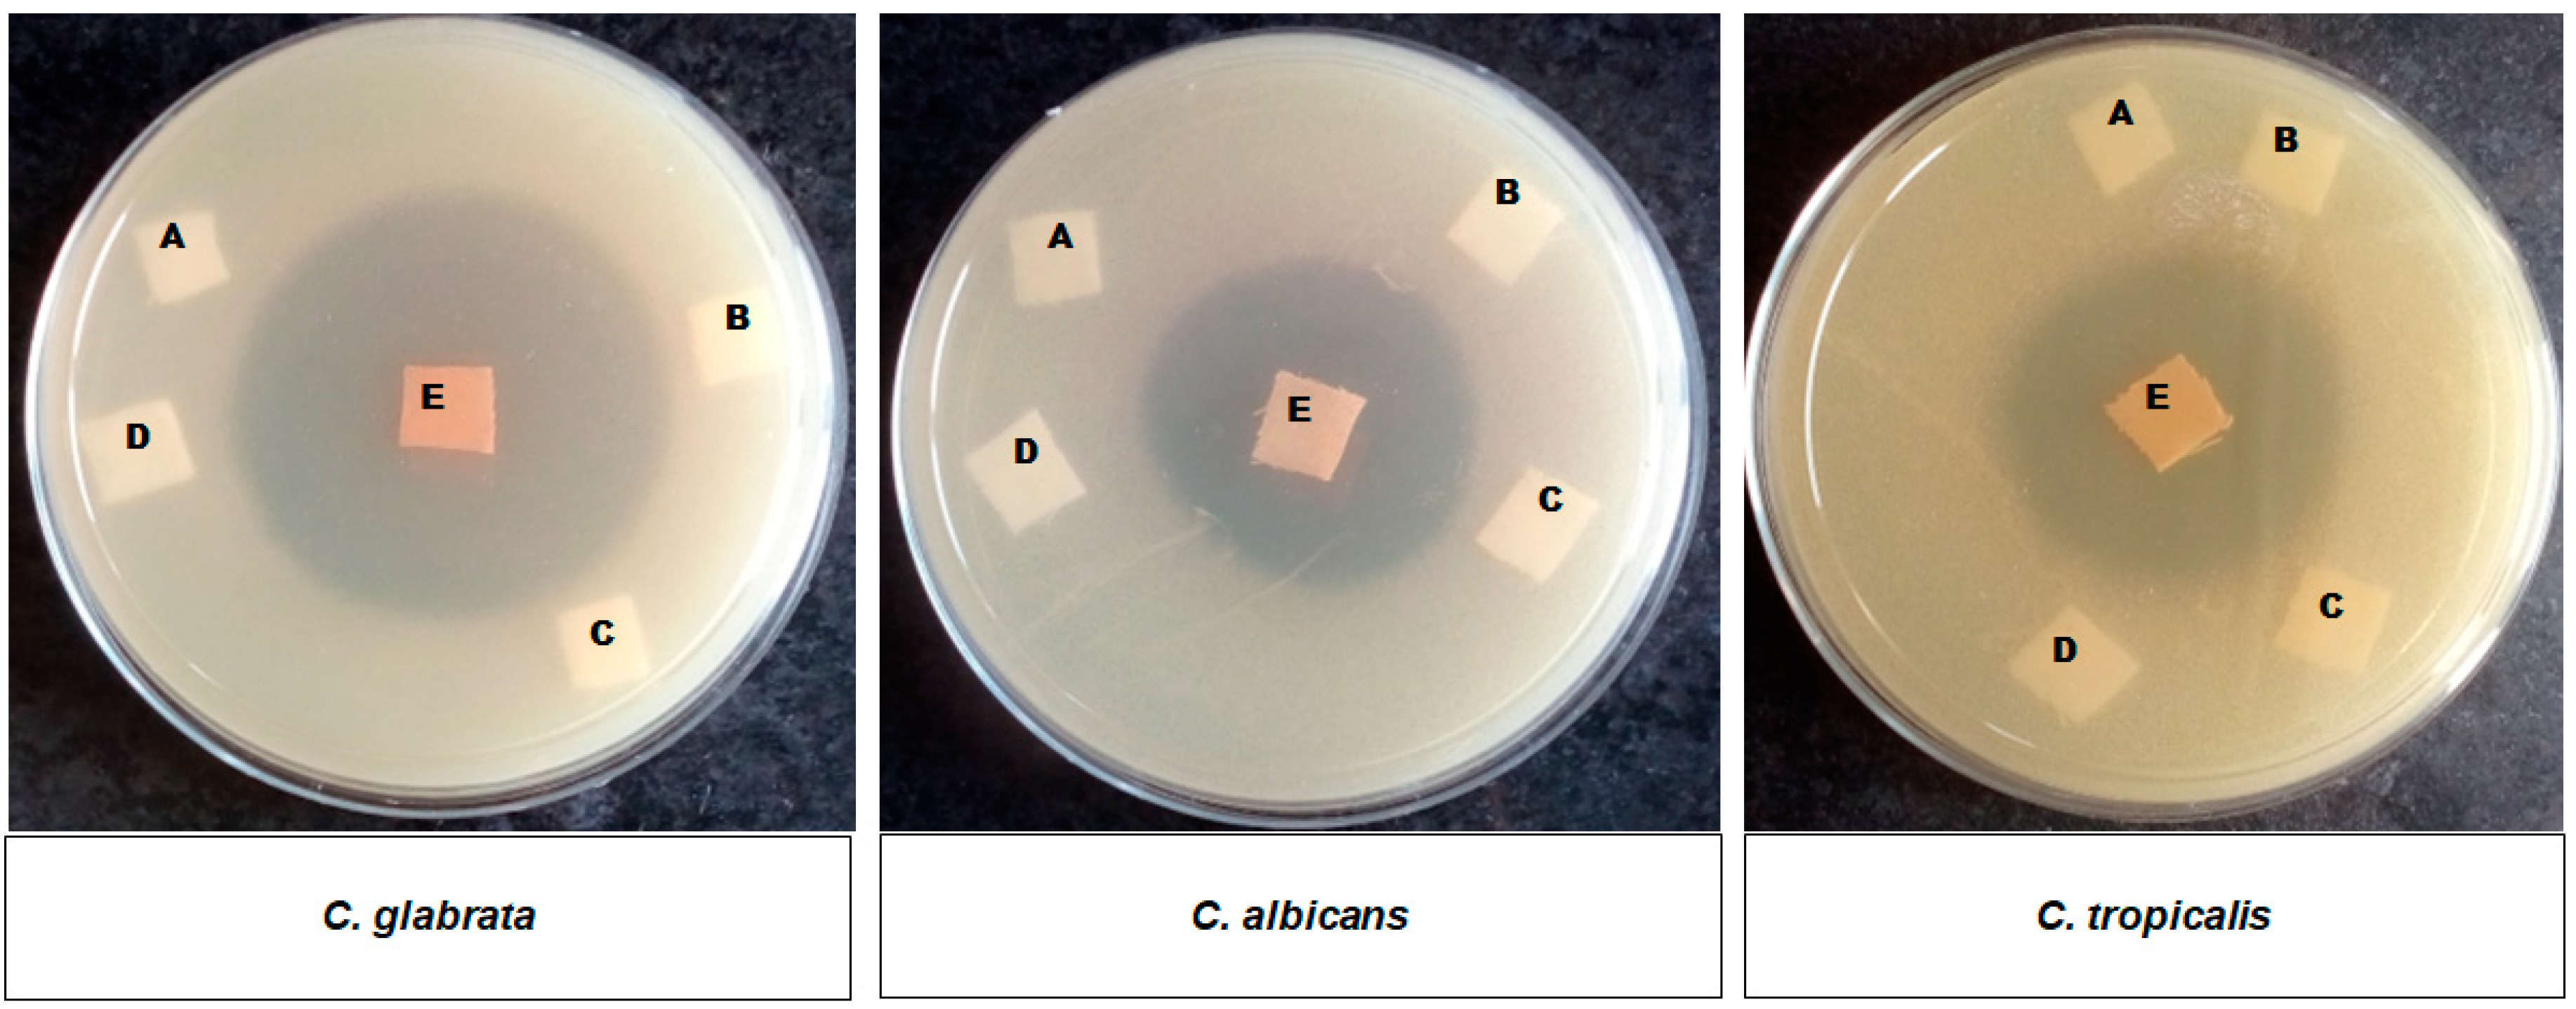
Fermentation 09 00018 g005 Fermentation 09 00018 g005

Development of Cost-Effective, Ecofriendly Selenium Nanoparticle-Functionalized Cotton Fabric for Antimicrobial and Antibiofilm Activity
Abstract
1. Introduction
2. Materials and Methods
2.1. Microorganisms and Culture Conditions
2.2. Chemicals
2.3. Coating of Se NPs on Cotton Fabric
Alkali Activation of Fabric
- (1)
- Physical adsorption of colloidal Se NPs on cotton fabric;
- (2)
- In situ synthesis of Se NPs on cotton fabric;
2.4. Characterization of Se-Coated Fabric
2.4.1. UV-Visible Diffuse Reflectance Spectroscopy (UV-Vis DRS)
2.4.2. Fourier-Transform Infrared (FTIR)
2.4.3. X-ray Diffraction (XRD)
- D: crystal size of Se NPs
- Β: full width at half maximum of the diffraction peak (Rad),
- λ: wavelength of X-ray source
- K: constant of Scherer equation (value range 0.9–1)
- θ: used in Radian
2.4.4. Scanning Electron Microscopy (SEM) and Energy Dispersive X-ray Spectroscopy (EDS)
2.4.5. Inductively Coupled Plasma-Optical Emission Spectrometry
2.5. Biological Activity
2.5.1. Determination of Antibacterial and Antifungal Property of Se-Coated Samples by Agar Plate Method
2.5.2. Determination of Antibiofilm Activity of Coated Fabric by Static Biofilm Method
2.5.3. SEM Analysis of Biofilm of Untreated and Se-Coated Fabrics
2.6. Washing Durability
2.7. Statistical Analysis
3. Results and Discussion
3.1. Synthesis and Coating of Se NPs on Cotton Fabric
3.2. Characterization Studies
3.2.1. UV-Visible Diffuse Reflectance Spectroscopy
3.2.2. Antimicrobial Efficacy of Coated Samples
Antibacterial Activity of Se-Coated-30
Antifungal Activity of Se-Coated-30
3.2.3. FT-IR Spectra of Se-Coated Fabric
3.2.4. XRD
3.2.5. SEM
3.2.6. ICP-OES
3.3. Antibiofilm Assay
3.4. SEM Analysis of Biofilm
3.5. Washing Durability of Se-Coated Fabric
4. Conclusions
Supplementary Materials
Author Contributions
Funding
Institutional Review Board Statement
Informed Consent Statement
Data Availability Statement
Acknowledgments
Conflicts of Interest
References
- Kim, H.; Tran, M.V.; Petryayeva, E.; Solodova, O.; Susumu, K.; Oh, E.; Medintz, I.L.; Algar, W.R. Affinity Immobilization of Semiconductor Quantum Dots and Metal Nanoparticles on Cellulose Paper Substrates. ACS Appl. Mater. Interfaces 2020, 12, 53462–53474. [Google Scholar] [CrossRef] [PubMed]
- Rai, M.; Shegokar, R. Metal Nanoparticles in Pharma; Springer International Publishing: Cham, Switzerland, 2017; pp. 1–493. [Google Scholar]
- Bhargava, A.; Pareek, V.; Roy Choudhury, S.; Panwar, J.; Karmakar, S. Superior bactericidal efficacy of fucose-functionalized silver nanoparticles against Pseudomonas aeruginosa PAO1 and prevention of its colonization on urinary catheters. ACS Appl. Mater. Interfaces 2018, 10, 29325–29337. [Google Scholar] [CrossRef] [PubMed]
- Basak, S.; Packirisamy, G. Nano-based antiviral coatings to combat viral infections. Nano-Struct. Nano-Objects 2020, 24, 100620. [Google Scholar] [CrossRef]
- Alam, H.; Khatoon, N.; Raza, M.; Ghosh, P.C.; Sardar, M. Synthesis and characterization of nano selenium using plant biomolecules and their potential applications. Bio Nano Sci. 2019, 9, 96–104. [Google Scholar] [CrossRef]
- Sardar, M.; Mazumder, J.A. Biomolecules assisted synthesis of metal nanoparticles. In Environmental Nanotechnology; Dasgupta, N., Ranjan, S., Lichtfouse, E., Eds.; Springer: Cham, Switzerland, 2019; Volume 21, pp. 1–23. [Google Scholar]
- Fazal, S.; Jayasree, A.; Sasidharan, S.; Koyakutty, M.; Nair, S.V.; Menon, D. Green synthesis of anisotropic gold nanoparticles for photothermal therapy of cancer. ACS Appl. Mater. Interfaces 2014, 6, 8080–8089. [Google Scholar] [CrossRef]
- Khatoon, N.; Ahmad, R.; Sardar, M. Robust and fluorescent silver nanoparticles using Artemisia annua: Biosynthesis, characterization and antibacterial activity. Biochem. Eng. J. 2015, 102, 91–97. [Google Scholar] [CrossRef]
- Khan, M.I.; Akhtar, M.N.; Ashraf, N.; Najeeb, J.; Munir, H.; Awan, T.I.; Tahir, M.B.; Kabli, M.R. Green synthesis of magnesium oxide nanoparticles using Dalbergia sissoo extract for photocatalytic activity and antibacterial efficacy. Appl. Nanosci. 2020, 10, 2351–2364. [Google Scholar] [CrossRef]
- Rajesh, K.; Ajitha, B.; Reddy, Y.A.K.; Suneetha, Y.; Reddy, P.S. Assisted green synthesis of copper nanoparticles using Syzygium aromaticum bud extract: Physical, optical and antimicrobial properties. Optik 2018, 154, 593–600. [Google Scholar] [CrossRef]
- Ali, J.; Mazumder, J.A.; Perwez, M.; Sardar, M. Antimicrobial effect of ZnO nanoparticles synthesized by different methods against food borne pathogens and phytopathogens. Mater. Today Proc. 2021, 36, 609–615. [Google Scholar] [CrossRef]
- Biswas, D.P.; O’Brien-Simpson, N.M.; Reynolds, E.C.; O’Connor, A.J.; Tran, P.A. Comparative study of novel in situ decorated porous chitosan-selenium scaffolds and porous chitosan-silver scaffolds towards antimicrobial wound dressing application. J. Colloid Interface Sci. 2018, 515, 78–91. [Google Scholar] [CrossRef]
- Kumar, M.; Tomar, M.; Amarowicz, R.; Saurabh, V.; Nair, M.S.; Maheshwari, C.; Sasi, M.; Prajapati, U.; Hasan, M.; Singh, S. Guava (Psidium guajava L.) leaves: Nutritional composition, phytochemical profile, and health-promoting bioactivities. Foods 2021, 10, 752. [Google Scholar] [CrossRef] [PubMed]
- Fouda, A.; Saad, E.; Salem, S.S.; Shaheen, T.I. In-Vitro cytotoxicity, antibacterial, and UV protection properties of the biosynthesized Zinc oxide nanoparticles for medical textile applications. Microb. Pathog. 2018, 125, 252–261. [Google Scholar] [CrossRef] [PubMed]
- Li, Y.-C.; Schulz, J.; Mannen, S.; Delhom, C.; Condon, B.; Chang, S.; Zammarano, M.; Grunlan, J.C. Flame retardant behavior of polyelectrolyte−clay thin film assemblies on cotton fabric. Acs Nano 2010, 4, 3325–3337. [Google Scholar] [CrossRef] [PubMed]
- Wang, Q.; Barnes, L.-M.; Maslakov, K.I.; Howell, C.A.; Illsley, M.J.; Dyer, P.; Savina, I.N. In situ synthesis of silver or selenium nanoparticles on cationized cellulose fabrics for antimicrobial application. Mater. Sci. Eng. C 2021, 121, 111859. [Google Scholar] [CrossRef] [PubMed]
- Borah, M.P.; Jose, S.; Kalita, B.B.; Shakyawar, D.; Pandit, P. Water repellent finishing on eri silk fabric using nano silica. J. Text. Inst. 2020, 111, 701–708. [Google Scholar] [CrossRef]
- Tudu, B.K.; Sinhamahapatra, A.; Kumar, A. Surface modification of cotton fabric using TiO2 nanoparticles for self-cleaning, oil–water separation, antistain, anti-water absorption, and antibacterial properties. ACS Omega 2020, 5, 7850–7860. [Google Scholar] [CrossRef]
- Xue, C.-H.; Chen, J.; Yin, W.; Jia, S.-T.; Ma, J.-Z. Superhydrophobic conductive textiles with antibacterial property by coating fibers with silver nanoparticles. Appl. Surf. Sci. 2012, 258, 2468–2472. [Google Scholar] [CrossRef]
- Seki, Y. Conductive cotton fabrics coated with myristic acid/zinc oxide nanoparticles. Polym. Plast. Technol. Eng. 2018, 57, 766–774. [Google Scholar] [CrossRef]
- Mitchell, A.; Spencer, M.; Edmiston, C., Jr. Role of healthcare apparel and other healthcare textiles in the transmission of pathogens: A review of the literature. J. Hosp. Infect. 2015, 90, 285–292. [Google Scholar] [CrossRef]
- Al-Shenqiti, A.; Bahashwan, S.; Ghanem, S.; Manzoor, N.; El, S.H. Nosocomial infections in intensive care and medical rehabilitation units, and evaluation of antibiotics prescription. Afr. J. Microbiol. Res. 2017, 11, 776–783. [Google Scholar] [CrossRef][Green Version]
- Tolera, M.; Abate, D.; Dheresa, M.; Marami, D. Bacterial nosocomial infections and antimicrobial susceptibility pattern among patients admitted at Hiwot Fana Specialized University Hospital, Eastern Ethiopia. Adv. Med. 2018, 2018, 2127814. [Google Scholar] [CrossRef] [PubMed]
- Wang, L.; Natan, M.; Zheng, W.; Zheng, W.; Liu, S.; Jacobi, G.; Perelshtein, I.; Gedanken, A.; Banin, E.; Jiang, X. Small molecule-decorated gold nanoparticles for preparing antibiofilm fabrics. Nanoscale Adv. 2020, 2, 2293–2302. [Google Scholar] [CrossRef] [PubMed]
- Yip, J.; Liu, L.; Wong, K.H.; Leung, P.H.; Yuen, C.W.M.; Cheung, M.C. Investigation of antifungal and antibacterial effects of fabric padded with highly stable selenium nanoparticles. J. Appl. Polym. Sci. 2014, 131. [Google Scholar] [CrossRef]
- Sadalage, P.S.; Nimbalkar, M.S.; Sharma, K.K.K.; Patil, P.S.; Pawar, K.D. Sustainable approach to almond skin mediated synthesis of tunable selenium microstructures for coating cotton fabric to impart specific antibacterial activity. J. Colloid Interface Sci. 2020, 569, 346–357. [Google Scholar] [CrossRef]
- Elmaaty, T.A.; Raouf, S.; Sayed-Ahmed, K.; Plutino, M.R. Multifunctional Dyeing of Wool Fabrics Using Selenium Nanoparticles. Polymers 2022, 14, 191. [Google Scholar] [CrossRef]
- Abou Elmaaty, T.; Sayed-Ahmed, K.; Elsisi, H.; Ramadan, S.M.; Sorour, H.; Magdi, M.; Abdeldayem, S.A. Novel Antiviral and Antibacterial Durable Polyester Fabrics Printed with Selenium Nanoparticles (SeNPs). Polymers 2022, 14, 955. [Google Scholar] [CrossRef]
- Perelshtein, I.; Perkas, N.; Gedanken, A. Ultrasonic Coating of Textiles by Antibacterial and Antibiofilm Nanoparticles. In Handbook of Ultrasonics and Sonochemistry; Ashokkumar, M., Ed.; Springer: Singapore, 2016; pp. 967–993. [Google Scholar]
- Yazdanshenas, M.E.; Shateri-Khalilabad, M. The effect of alkali pre-treatment on formation and adsorption of silver nanoparticles on cotton surface. Fibers Polym. 2012, 13, 1170–1178. [Google Scholar] [CrossRef]
- Nawaz, R.; Naqvi, S.T.R.; Fatima, B.; Zulfiqar, N.; Farooq, M.U.; Hussain, D.; Javeed, A.; Rasul, A.; Jafri, L.; Majeed, S. Cost-effective fabrication, antibacterial application and cell viability studies of modified nonwoven cotton fabric. Sci. Rep. 2022, 12, 2493. [Google Scholar] [CrossRef]
- Scherrer, P. Göttinger nachrichten math. Phys 1918, 2, 98–100. [Google Scholar]
- Huang, L.; Tong, X.; Li, Y.; Teng, J.; Bai, Y. Preparation of a novel supported selenium nanoparticles adsorbent and its application for copper removal from aqueous solution. J. Chem. Eng. Data 2015, 60, 151–160. [Google Scholar] [CrossRef]
- Pinho, E.; Magalhães, L.; Henriques, M.; Oliveira, R. Antimicrobial activity assessment of textiles: Standard methods comparison. Ann. Microbiol. 2011, 61, 493–498. [Google Scholar] [CrossRef]
- El-Shishtawy, R.M.; Asiri, A.M.; Abdelwahed, N.A.; Al-Otaibi, M.M. In situ production of silver nanoparticle on cotton fabric and its antimicrobial evaluation. Cellulose 2011, 18, 75–82. [Google Scholar] [CrossRef]
- Hossain, M.A.; Lalloz, A.; Benhaddou, A.; Pagniez, F.; Raymond, M.; Le Pape, P.; Simard, P.; Théberge, K.; Leblond, J. Econazole imprinted textiles with antifungal activity. Eur. J. Pharm. Biopharm. 2016, 101, 137–144. [Google Scholar] [CrossRef] [PubMed]
- Yazdanshenas, M.E.; Shateri-Khalilabad, M. In situ synthesis of silver nanoparticles on alkali-treated cotton fabrics. J. Ind. Text. 2013, 42, 459–474. [Google Scholar] [CrossRef]
- Shateri-Khalilabad, M.; Yazdanshenas, M.E.; Etemadifar, A. Fabricating multifunctional silver nanoparticles-coated cotton fabric. Arab. J. Chem. 2017, 10, S2355–S2362. [Google Scholar] [CrossRef]
- Alam, H.; Khatoon, N.; Khan, M.A.; Husain, S.A.; Saravanan, M.; Sardar, M. Synthesis of selenium nanoparticles using probiotic bacteria Lactobacillus acidophilus and their enhanced antimicrobial activity against resistant bacteria. J. Clust. Sci. 2020, 31, 1003–1011. [Google Scholar] [CrossRef]
- Huang, T.; Holden, J.A.; Heath, D.E.; O’Brien-Simpson, N.M.; O’Connor, A.J. Engineering highly effective antimicrobial selenium nanoparticles through control of particle size. Nanoscale 2019, 11, 14937–14951. [Google Scholar] [CrossRef]
- Emara, A.A.; El-Hameed, F.S.A.; Khalil, S.M. Intermediates in the thermal decomposition of normal copper (II), nickel (II) and cobalt (II) selenite dihydrates. Phosphorus Sulfur Silicon Relat. Elem. 1996, 114, 1–15. [Google Scholar] [CrossRef]
- Nithya, E.; Radhai, R.; Rajendran, R.; Shalini, S.; Rajendran, V.; Jayakumar, S. Synergetic effect of DC air plasma and cellulase enzyme treatment on the hydrophilicity of cotton fabric. Carbohydr. Polym. 2011, 83, 1652–1658. [Google Scholar] [CrossRef]
- Manian, A.P.; Braun, D.E.; Široká, B.; Bechtold, T. Distinguishing liquid ammonia from sodium hydroxide mercerization in cotton textiles. Cellulose 2022, 29, 4183–4202. [Google Scholar] [CrossRef]
- Lee, S.; Ahn, S.; Lee, H.; Kim, J. Layer-by-layer coating of MIL-100 (Fe) on a cotton fabric for purification of water-soluble dyes by the combined effect of adsorption and photocatalytic degradation. RSC Adv. 2022, 12, 17505–17513. [Google Scholar] [CrossRef] [PubMed]
- Wang, X.; Chang, L.; Shi, X.; Wang, L. Effect of hot-alkali treatment on the structure composition of jute fabrics and mechanical properties of laminated composites. Materials 2019, 12, 1386. [Google Scholar] [CrossRef] [PubMed]
- Foss, O.; Janickis, V. Crystal structure of γ-monoclinic selenium. J. Chem. Soc. Dalton Trans. 1980, 624–627. [Google Scholar] [CrossRef]
- Prasanth, S.; Sudarsanakumar, C. Elucidating the interaction of L-cysteine-capped selenium nanoparticles and human serum albumin: Spectroscopic and thermodynamic analysis. New J. Chem. 2017, 41, 9521–9530. [Google Scholar] [CrossRef]

| Zone of Inhibition (mm) | ||||
|---|---|---|---|---|
| Samples | E. coli | S. aureus | K. pneumonia | C. albicans |
| Se-coated-10 | - | 10 ± 0.3 | 12 ± 0.2 | 12 ± 0.4 |
| Se-coated-20 | 12 ± 0.5 | 20 ± 0.5 | 23 ± 0.3 | 20 ± 0.3 |
| Se-coated-30 | 16 ± 0.3 | 32 ± 0.7 | 26 ± 0.3 | 35 ± 0.4 |
| Se-coated-40 | 16 ± 0.5 | 32 ± 0.4 | 28 ± 0.1 | 36 ± 0.3 |
| Experimental Peaks Frequency (cm−1) Obtained | |||||
|---|---|---|---|---|---|
| Literature (cm−1) | Uncoated Fabric | Activated Fabric | Se-Coated-30 | Peak Characteristics | Ref. |
| 3570–3200 | 3330 | 3330 | 3316–3083 | O6-H str | [42] |
| 3000–2800 | 2886 | 2892 | 2892 | C6-H str | [42] |
| 1430 | 1424 | 1423 | 1420 | CH wagging | [42] |
| 1372 | 1365 | 1363 | 1366 | CH bending | [42] |
| 1163 | 1156 | 1160 | 1157 | C5-O-C1 | [43] |
| 893 | 894 | 894 | 894 | C1-O-C4; β-glucosidic bond | [43] |
| 760–870 | - | - | 788 | Se-O sym str | [41] |
| Percent Reduction (R%) | ||
|---|---|---|
| Microbes | Before Wash | After 30 Wash |
| E. coli | 60 ± 2 | 58 ± 1 |
| S. aureus | 80 ± 3 | 79 ± 2 |
| C. albicans | 100 ± 1 | 99.9 ± 1 |
Disclaimer/Publisher’s Note: The statements, opinions and data contained in all publications are solely those of the individual author(s) and contributor(s) and not of MDPI and/or the editor(s). MDPI and/or the editor(s) disclaim responsibility for any injury to people or property resulting from any ideas, methods, instructions or products referred to in the content. |
© 2022 by the authors. Licensee MDPI, Basel, Switzerland. This article is an open access article distributed under the terms and conditions of the Creative Commons Attribution (CC BY) license (https://creativecommons.org/licenses/by/4.0/).
Share and Cite
Mirza, K.; Naaz, F.; Ahmad, T.; Manzoor, N.; Sardar, M. Development of Cost-Effective, Ecofriendly Selenium Nanoparticle-Functionalized Cotton Fabric for Antimicrobial and Antibiofilm Activity. Fermentation 2023, 9, 18. https://doi.org/10.3390/fermentation9010018
Mirza K, Naaz F, Ahmad T, Manzoor N, Sardar M. Development of Cost-Effective, Ecofriendly Selenium Nanoparticle-Functionalized Cotton Fabric for Antimicrobial and Antibiofilm Activity. Fermentation. 2023; 9(1):18. https://doi.org/10.3390/fermentation9010018
Chicago/Turabian StyleMirza, Kainat, Farha Naaz, Tokeer Ahmad, Nikhat Manzoor, and Meryam Sardar. 2023. "Development of Cost-Effective, Ecofriendly Selenium Nanoparticle-Functionalized Cotton Fabric for Antimicrobial and Antibiofilm Activity" Fermentation 9, no. 1: 18. https://doi.org/10.3390/fermentation9010018
APA StyleMirza, K., Naaz, F., Ahmad, T., Manzoor, N., & Sardar, M. (2023). Development of Cost-Effective, Ecofriendly Selenium Nanoparticle-Functionalized Cotton Fabric for Antimicrobial and Antibiofilm Activity. Fermentation, 9(1), 18. https://doi.org/10.3390/fermentation9010018

